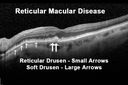
rmd_thjo_022312_20.jpg

|
|

Diabetic Retinopathy1314 viewsAnnual diabetic exam. VA 20/30, right eye and 20/50, left eye. Fundus photos shows hemorrhages with cotton wool spots. Exudates are visible around the macula in the right eye. Scattered hemorrhages in the left eye.
|
|

Bilateral Diffuse Uveal Melanocytic Proliferation - BDUMP - Paraneoplastic Syndrome1313 views80-year-old man vision loss for one year. He died about one year after these photos from Metastatic Poorly Differentiated Large Cell Carcinoma of unknown primary. He was a smoker.
|
|

1313 views
|
|

Asteroid Hyalosis - Benign Calcified Deposits in the Vitreous1312 views75 year old woman with 20/30 vision and dense asteroid haylosis
|
|

Central Serous Retinopathy - Acute1311 views49-year-old man sees a spot in the central vision with a red halo for 2 weeks OD is 20/50, OS is 20/20
|
|

Fundus Flavimaculatus - Stargardt Disease - 20/50 OD 20/200 OS 61 Year old Color Photo1310 views61-year-old decreasing vision for about the last five years. OD 20/50, OS 20/200.
Pisciform Lesions and Macular Atrophy
|
|

Horseshoe Retinal Tear 1310 views
|
|

Acute Posterior Multifocal Placoid Pigment Epitheliopathy - APMPPE - SD-OCT 1310 views 25-year-old man with one and half weeks ago he woke up with night chills. Also around that time his joints started hurting him. He also has headaches, although the headache at this point is not severe. His vision has been changing for about the last week and a half. He sees some spots in his vision and they are blurred spots. They are not in the central vision.
VISUAL ACUITY: OD 20/32, OS 20/32
|
|

Choroidal Rupture and small Hemorrhage - Assault1307 views34 year old man. The patient reports he was assaulted by a couple of adolescents near downtown St. Petersburg about forty-eight hours ago. He reports the pain in the left eye has significantly improved, but his vision is a little fuzzy and he sees some floaters in the left eye. 20/125 OD, 20/20 OS. Pinhole improves in the right eye to 20/50. IOP: 15 OD, 13 OS.
SLIT LAMP EXAMINATION: Biomicroscopy reveals 3+ pupillary reaction OD, 2+ OS with no afferent pupillary defect. EXTENDED OPHTHALMOSCOPY: Extended funduscopy with Volk 90-diopter lens and fundus drawings of both eyes reveal a clear view with no posterior vitreous separation. C/D ratio is 0.2. There is no vitreous debris or hemorrhage. Large retinal vessels and macula are healthy. The retinal periphery, inspected with scleral depression for 360° shows no retinal tears, breaks, or detachments.
|
|

Acute Central Serous Retinopathy - Classic Smokestack on Fluorescein Angiogram - Animated .GIF1307 views34-year-old man noticed about five days ago decreased vision in the right eye. He was having difficulty playing video games and seeing with that eye. He thought maybe his refractive error was shifting.
VISUAL ACUITY: Vision OD is 20/40, OS is 20/16
|
|

Papilledema - Spectral Domain OCT used for Diagnosis - 14 year old Child - Nerve Fiber Layer Scan shows swelling1307 views14-year-old was with optic nerve swelling asymptomatic - picked up during routine eye exam. OD 20/20, OS 20/32
SD-OCT is used to differentiate optic disc edema from optic nerve head drusen (which are not yet calcified in children).
|
|

Retinitis Pigmentosa - Leber's Congenital Amaurosis - 7 Year Old Child -Fundus Photo Right Eye - Periphery1306 views7-year-old child who trips over things that the other children do not have trouble seeing. She is the only person in the family tree that the mother knows has any vision problems. Vision is 20/20 in each eye
|
|

Acute Central Serous Retinopathy - Classic Smokestack on Fluorescein Angiogram 1305 views34-year-old man noticed about five days ago decreased vision in the right eye. He was having difficulty playing video games and seeing with that eye. He thought maybe his refractive error was shifting.
VISUAL ACUITY: Vision OD is 20/40, OS is 20/16
|
|

Anterior Ischemic Optic Neuropathy - Non-Arteritic - AION1304 views72-year-old woman sudden vision loss in the right eye about four days ago. She also has noticed that things are dim out of that eye. She has no headaches. She does feel a little tired. She has no pain in her jaw when she chews and she has no fevers.
OD is 20/80, PH 20/25; OS is 20/25
|
|

Capillary Non-Perfusion - Severe Non-Proliferative (Background) Diabetic Retinopathy - Type I - 20 Year Old Man Diabetic 16 years1303 views20 year old diabetic with poor vision for the past three or four years. He has been diabetic for sixteen years and hemoglobin A1C of 10.0. 20/25 OD, 20/30 OS.
|
|

Bilateral Diffuse Uveal Melanocytic Proliferation - BDUMP - Paraneoplastic Syndrome1301 views80-year-old man vision loss for one year. He died about one year after these photos from Metastatic Poorly Differentiated Large Cell Carcinoma of unknown primary. He was a smoker.
|
|

Central Serous Retinopathy Acute - Fundus Autofluorescence1300 views42-year-old man was seen in the office on October 5, 2011. He had noticed starting in August after a course of antibiotic and steroids, that he developed new spots in his vision in the right eye. He may have had an episode like this sometime in the past. He did take steroids a few years ago and his vision did change at that time, but then returned.
VISUAL ACUITY: OD 20/32, OS 20/32
|
|

wyburn-mason sydrome1299 views28 year old female, visual acuity OS 20/200
|
|

Retinocytoma - Retinoma - Regressed Retinoblastoma 43 year old male incidental finding 1298 views
|
|

Progressive Outer Retinal Necrosis 77 Year Old Woman with CLL (Acute Retinal Necrosis) (PORN - ARN)1296 views77-year-old woman with CLL who had shingles on the left side of her face about 6 weeks ago then she developed a dendrite in the cornea which was treating about four weeks ago. She noticed severe vision loss in the left eye just a few days ago and you saw retinitis and she comes in because of that. Vision OD is 20/25, OS is hand motion
|
|

Peripheral Bullous Retinoschisis Spectral Domain Optical Coherence Tomography (SD-OCT)1295 views64-year-old man with peripheral retinal problem noted during comprehensive eye examination. OD 20/32, OS 20/25
|
|

Non-Kissing Choroidals 1294 viewsFluid and blood underneath the choroid nasally and temporally after cataract surgery in the left eye
|
|

Hemi Central Retinal Vein Occlusion 35 year old non-compliant man1292 views35-year-old man hazy vision in his left eye for about the last three days. OD 20/20, OS 20/30
|
|

80 year old woman with Reticular Drusen (pseudodrusen) 20/30 Vision1291 views80 year old woman with asteroid hyalosis and macular degeneration.
OPHTHALMIC EXAMINATION: Visual acuity with correction 20/30-3 OD and 20/30-2
|
|

Retinal Coloboma1291 views14-year old male presents with decreased vision in the left eye. Dx with iris and retinal coloboma in the left eye. Patient VA was 20/20, right eye, 20/100 left eye with pinhole improvement 20\50. Patient was fitted for SCL in the left eye.
|
|

Acute Central Serous Retinopathy - Classic Smokestack on Fluorescein Angiogram 1290 views34-year-old man noticed about five days ago decreased vision in the right eye. He was having difficulty playing video games and seeing with that eye. He thought maybe his refractive error was shifting.
VISUAL ACUITY: Vision OD is 20/40, OS is 20/16
|
|

Coats' Disease1289 views11 year old male seen for trauma to OS from a volleyball. After examination, it was determined the pt had Coat's Disease. VA 20/20 OD 20/60 OS. FA confirmed the diagnosis.
|
|

Choroidal Melanoma - Exudative Retinal Detachment 82 Year Old Man B Scan - Transverse1288 views82-year-old man who had 3 falls 2 weeks ago. After the falls he started checking his vision and noticed there was a veil over the left eye, which he had seen for about two weeks in the superior visual field. OD 20/25, OS 20/40
(patient was medically never well enough for brachytherapy and died 6 months later from heart disease)
|
|

Low Tension Glaucoma1286 views59-year-old woman has a history of glaucoma dating back to 1990. She had trabeculectomy in the left eye in 1998 and then persisted to lose vision despite normal intraocular pressures from low-tension glaucoma in the left eye. She is now on Cosopt and Travatan in both eyes.
Vision OD is 20/20, OS is 20/16. IOP: OD 9, OS 6.
|
|

Endophthalmitis with Hypopion1285 views
|
|

Vogt–Koyanagi–Harada Syndrome OS1285 views43 yr old Italian Male with VKH in both eyes.
|
|

Pigmented Peripheral Retinal Degeneration1284 views42-year old male comes in for routine eye exam and to follow up on peripheral retinal degeneration in both eyes. VA is 20/20, right eye and 20/25, left eye. Patient is asymptomatic with no visual complaints.
|
|

Rubeosis Iridis1282 viewsPatient presents with Rubeosis Iridis in the right eye due to neovascular glaucoma. VA is 20/40 in the right eye. Will follow up in 3-months.
|
|

Best Disease - Left Eye Treated Previously, Elsewhere, with PDT and Avastin1281 views11-year-old has Best’s disease that runs in his family on his mothers side. At another retina specialists office, he had photodynamic laser in April of 2009 and Avastin subsequently in June of 2009. Unfortunately with that his vision is substantially declining. OD 20/30, OS 20/100
|
|

Sturge-Weber Encephalotigeminal Angiomatosis - Facial Hemangioma and Ipsilateral Diffuse Choroidal Hemangioma1281 views61-year-old man with Sturge-Weber syndrome with a hemangioma on the left side of his face.
VISUAL ACUITY: Vision OD is 20/50, PH 20/30; OS 20/80, PH 20/30. IOP: OD 16, OS 19.
|
|

Acute Central Serous Retinopathy - Classic Smokestack on Fluorescein Angiogram - OCT1279 views34-year-old man noticed about five days ago decreased vision in the right eye. He was having difficulty playing video games and seeing with that eye. He thought maybe his refractive error was shifting.
VISUAL ACUITY: Vision OD is 20/40, OS is 20/16
|
|

Propionibacterium acnes endophthalmitis with capsular plaque and uveitis1276 views61 year old man with inflammation after cataract surgery who ultimately needed removal of intraocular lens and capsule to quiet eye.
|
|

Reticular Macular Disease (Pseudo-drusen) Both Eyes - Wet AMD OS - Dry AMD OD SD-OCT1276 views84-year-old woman has wet age-related macular degeneration in the left eye and dry macular degeneration in the right eye. She takes the eye vitamins and her vision is stable since she was treated three months ago with Avastin. OD 20/50, OS 20/32
|
|

Acute Central Serous Retinopathy - Classic Smokestack on Fluorescein Angiogram 1276 views34-year-old man noticed about five days ago decreased vision in the right eye. He was having difficulty playing video games and seeing with that eye. He thought maybe his refractive error was shifting.
VISUAL ACUITY: Vision OD is 20/40, OS is 20/16
|
|

Acute Posterior Multifocal Placoid Pigment Epitheliopathy - APMPPE - SD-OCT 1275 views 25-year-old man with one and half weeks ago he woke up with night chills. Also around that time his joints started hurting him. He also has headaches, although the headache at this point is not severe. His vision has been changing for about the last week and a half. He sees some spots in his vision and they are blurred spots. They are not in the central vision.
VISUAL ACUITY: OD 20/32, OS 20/32
|
|
Reticular Macular Disease (Pseudo-drusen) Both Eyes - Occult CNVM and Macular Edema Right Eye 1275 viewsSpectral Domain Optical Coherence Tomography
|
|

Bilateral Macular Star1275 viewsYoung female patient comes in with blurred vision in both eyes. VA is 20/40 in both eyes. Fundus photos show visible macular star centrally in both eyes. This is a result of Bilateral Neuroretinitis due to cat scratch.
|
|

"Jelly Bumps" Soft Contact Lens1275 viewsYoung female patient comes in wearing overnight contact lenses. Complains of irritation in both eyes. Denies sleeping in SCL. Slit lamp exam shows little jelly bumps underneath the contact lens in both eyes. Was issued a new pair and lectured on handling them.
|
|

Retinal Tear Before Laser1274 views65-year-old woman new onset floaters for 1 week. She initially saw flashing lights and then the flashing lights subsided and then she had the floaters VISUAL ACUITY: OD 20/25, OS 20/50
|
|

Optic Nerve Drusen in 7 Year Old Child - Miminal Calcification1273 views7-year-old child difficulty seeing the blackboard in school. She was checked for glasses and it was noted at that time that she had unusual looking optic nerves. Vision OU is 20/50.
|
|

Acute Central Serous Retinopathy - Classic Smokestack on Fluorescein Angiogram 1273 views34-year-old man noticed about five days ago decreased vision in the right eye. He was having difficulty playing video games and seeing with that eye. He thought maybe his refractive error was shifting.
VISUAL ACUITY: Vision OD is 20/40, OS is 20/16
|
|

Silicone Oil Bubbles in the Angle1271 viewsPatient is evaluated for glaucoma associated with ocular inflammation. VA is CF in the right eye and 20/50, left eye. Gonioscopy photos shows little silicone oil bubbles in the inferior angle of the right eye. Patient to consider removal of silicone oil.
|
|

Diabetic Macular Edema Left Eye - Post Laser1266 views82-year-old woman diabetic for many years, last eye exam 5 years ago with gradual vision loss. OD 20/60, OS 20/70. IOP: OD 16, OS 17.
|
|

Basal Laminar Drusen - Cuticular Drusen - 19 Year Old with Lupus Nephritis1265 views19-year-old. She has a history of developing severe systemic lupus erythematosus in 2001. She was in renal failure and had biopsy proven Class 2 lupus nephritis. She is currently on Plaquenil 400 mg for six years, as well as Prednisolone orally, every other day. OD 20/20, OS 20/25.
|
|

Optic Nerve (Disc) Drusen - Fundus Autofluorescence1265 views34 Year Old woman no headaches normal vision
|
|

Asymptomatic Hollenhorst Plaque - Cholesterol Embolis1264 views71-year-old woman is not noticing any vision change. She does take pressure-lowering drops for glaucoma, both Timolol and Xalatan.
VISUAL ACUITY: Vision OD is 20/30, OS is 20/16
|
|

Iris Neovascularization secondary to Central Retinal Artery Occlusion1264 views
|
|

Central Areolar Choroidal Dystrophy1264 viewsPatient wanted second opinion for atrophic macular degeneration. VA is 20/400, right eye and 20/100. left eye. Patient has very poor vision and also hearing impaired. Fundiscopic exam reveals very atrophy in the macula. FAF shows a central hole to the choroid with no neovascularization present.
|
|

Unilateral Hemorrhagic Retinopathy1262 viewsA 53 yr-old male was referred for a Macular Aneurysm. The FA should no apparent Aneurysm, nor did it show any evident VO or Edema. The patient is in the Navy but hadn't gone on any deep sea dives or any air flights.
The cause of the hemorrhages is unknown, the following ARVO abstract from 2012 identifies similar cases found in females.
Clinical Features Of Unilateral Hemorrhagic Retinopathy: A New Retinal Entity?
Presentation Start/End Time: Wednesday, May 09, 2012, 1:45 PM - 3:30 PM
Session 466
|
|

Hyperpigmentation of the Retinal Pigment Epithelium in Dry AMD1260 views87-year-old woman has wet age-related macular degeneration in the left eye. Vision OD is 20/25, OS is 20/400
|
|

Macular Telangiectasis (Group 2a Juxtafoveal Telangiectasis) Decreased Fundus Autofluorescence1260 views63-year-old woman has juxtafoveal retinal telangiectasis in both eyes. She notices her vision a little worse with more distortion and change over the last six months.
VISUAL ACUITY: OD 20/40, OS 20/40.
|
|

Optic Nerve Pit1260 viewsOptic Nerve Pit
|
|

Retinal Flap Tear - Horseshoe - Cystic Retinal Tuft on Flap1259 views73-year-old woman who noticed two days ago she was bending over and had a sudden “ribbon†in her
vision which looked to her like blood. VISUAL ACUITY: Vision OD is 20/25, OS is 20/20.
|
|

Fundus Flavimaculatus - Stargardt Disease - 20/50 OD 20/200 OS 61 Year old - SD OCT OD1259 views61-year-old decreasing vision for about the last five years. OD 20/50, OS 20/200.
Pisciform Lesions and Macular Atrophy
|
|

Sickle Cell1258 views
|
|

Probable Measles Retinopathy1255 views52-year old female wanted second opinion on retinal eval. Patient had PK and PDT in the left eye. VA was 20/30, right eye was count fingers. Pinhole was NI, both eyes. Patient's mother had measles. Notice pigment changes in both the color and FAF photo.
|
|

Asteroid Hyalosis Before Vitrectomy1253 views80 year old woman with decreased vision and blurring in the left eye for the past year. She reports that she has blurring that comes and goes and floaters that bother her when she reads.
The patient reports that the floaters that bother her have been occurring on a daily basis lately. She reports that she is having a “hard time readingâ€.
Visual acuity with correction 20/30-3 OD and 20/30-2
|
|

Best Disease - Left Eye Treated Previously, Elsewhere, with PDT and Avastin1252 views11-year-old has Best’s disease that runs in his family on his mothers side. At another retina specialists office, he had photodynamic laser in April of 2009 and Avastin subsequently in June of 2009. Unfortunately with that his vision is substantially declining. OD 20/30, OS 20/100
|
|

Optic Nerve Head Drusen Left Eye1252 views57-year-old woman has optic nerve drusen in both eyes.
VISUAL ACUITY: OU 20/20.
|
|

Choroidal Osteoma1252 viewsPatient with decreased vision within the past 2-years. VA 20/100 in the right eye. Fundus photo shows atrophic scar temporal to the macula in the right eye.
|
|

Cornea Ulcer/Abrasion1251 views
|
|

Choroidal Melanoma with Retinal Detachment1251 views57 year old female who underwent proton beam therapy for Choroidal Melanoma. VA was 20/400 at post op visit.
|
|

360-Degree's Pseudoexfoliation1250 viewsFollow-up on glaucoma. Patient has sever pseudoexfoliation in the right eye. VA is 20/25 with IOP at 27. Patient will return in 6-months for re-evaluation.
|
|

Foreign Body "Rust Ring" 1250 viewsPatient complained of redness and tearing with white discharge. Patient was working with a grinding wheel on a vehicle. Slit lamp exam shows a rust ring barley off center. FBS was removed with Algiers Brush.
|
|

"Jelly Bumps" Soft Contact Lens1249 viewsYoung female patient comes in wearing overnight contact lenses. Complains of irritation in both eyes. Denies sleeping in SCL. Slit lamp exam shows little jelly bumps underneath the contact lens in both eyes. Was issued a new pair and lectured on handling them.
|
|

Plaquenil Toxicity - Bulls Eye Maculopathy1248 views70-year-old woman with systemic Lupus erythematosus and clotting problems. She was on the Plaquenil for about eight years and then off the Plaquenil for the last eight years because she developed macular toxicity. Although her vision was hazy, it was stable. Recent deceased vision left eye: OD 20/60, OS 20/100. IOP: OD 18, OS 19.
|
|

New Subfoveal Classic CNVM OS - Wet AMD - Macular Scar Congenital Toxoplasmosis Right Eye 1248 views77-year-old woman as had poor vision in the right eye since birth from congenital toxoplasmosis of her macula in the right eye. Two to three weeks ago when she noticed vision loss in the left eye. VISUAL ACUITY: OD 2/200, OS 20/200.
|
|

CHRPE - Congenital Hypertrophy of the Pigment Epithelium - Peripheral1247 views55-year-old woman OD 20/30, OS 20/25
|
|

Microaneurysms from Ocular Ischemic Syndrome (non-diabetic) Right Eye - Left eye CRAO 1 year ago1246 views66-year-old woman lost vision in the left eye from a central retinal artery occlusion 1 year ago. Vision OD is fine. OD 20/25, OS 20/50
|
|

Acute Central Serous Retinopathy - Classic Smokestack on Fluorescein Angiogram 1245 views34-year-old man noticed about five days ago decreased vision in the right eye. He was having difficulty playing video games and seeing with that eye. He thought maybe his refractive error was shifting.
VISUAL ACUITY: Vision OD is 20/40, OS is 20/16
|
|

Best Disease - SD OCT Line Scan1245 views
|
|

Acute Central Serous Retinopathy - Classic Smokestack on Fluorescein Angiogram 1244 views34-year-old man noticed about five days ago decreased vision in the right eye. He was having difficulty playing video games and seeing with that eye. He thought maybe his refractive error was shifting.
VISUAL ACUITY: Vision OD is 20/40, OS is 20/16
|
|

Coats' Disease with Cryotherapy 1244 viewsYoung male with Coat's Disease with Cryotherapy in the right eye. VA was 20/20, right eye. Left eye was completely normal. Patient will be followed up in 3-months.
|
|

Psuedo-retinitis Pigmentosa - Bone Spicules One Eye - Probably Acute Zonal Occult Outer Retinopathy (AZOOR)1242 views65-year-old woman has pseudoretinitis pigmentosa in the right eye only, most likely from acute zonal occult outer retinopathy. OD 20/25, OS 20/25
|
|

Gonioscopy; Scattered Peripheral Anterior Synechiae1242 viewsPatient comes in for evaluation for glaucoma. Patient also has a history of Uveitis. Last flare up was back in 1990. Patient's VA was 20/30, Right eye and 20/40-1, Left eye. Slit Lamp Gonioscopy reveals iris bow with scattered PAS around the angles of the anterior chamber. You can also see pigmentation in the trabecular meshwork. Patient will follow up in 3-months.
|
|

Endophthalmitis with Hypopion1239 views
|
|

Acute Central Serous Retinopathy - Classic Smokestack on Fluorescein Angiogram 1239 views34-year-old man noticed about five days ago decreased vision in the right eye. He was having difficulty playing video games and seeing with that eye. He thought maybe his refractive error was shifting.
VISUAL ACUITY: Vision OD is 20/40, OS is 20/16
|
|

Central Serous Retinopathy Acute - Fluorescein Angiogram1238 views42-year-old man was seen in the office on October 5, 2011. He had noticed starting in August after a course of antibiotic and steroids, that he developed new spots in his vision in the right eye. He may have had an episode like this sometime in the past. He did take steroids a few years ago and his vision did change at that time, but then returned.
VISUAL ACUITY: OD 20/32, OS 20/32
|
|

2 - Horseshoe Tears1237 views
|
|

Occult Maculopathy - Thin Fovea on OCT and Normal Color VA, Photos, FA VA 20/80 OU1236 views45-year-old man OCT scan shows foveal thinning
|
|

Acute Central Serous Retinopathy - Classic Smokestack on Fluorescein Angiogram 1236 views34-year-old man noticed about five days ago decreased vision in the right eye. He was having difficulty playing video games and seeing with that eye. He thought maybe his refractive error was shifting.
VISUAL ACUITY: Vision OD is 20/40, OS is 20/16
|
|

Best Disease Fundus Autofluorescence1234 views
|
|

Retinal Tear Before Laser1232 views65-year-old woman new onset floaters for 1 week. She initially saw flashing lights and then the flashing lights subsided and then she had the floaters VISUAL ACUITY: OD 20/25, OS 20/50
|
|

Uveitis - Iris Nodule - Koeppe Nodule1231 views29-year-old woman has had problems with uveitis in the right eye for about the last two years. Her symptoms are usually floaters. Occasionally the eye gets red, it has not been very uncomfortable, and it has always been in the right eye. Has had Iris Nodule like one in photo in left eye and Right eye. They clear with or without steroids after about a month.
|
|

A case of DUSN-11231 views
|
|

Proliferative Diabetic Retinopathy1231 viewsFundus photography shows severe fibrosis and arterial narrowing. Peripheral laser scars in both eyes. VA is 20/40, right eye and 20/50, left eye.
|
|

Malignant Hypertension - Cotton Wool Spots - Elschnig Spots - Optic Nerve Edema 1230 viewsElschnig Spots are pigment spots in periphery
|
|

Chorodial Melanoma1230 views80 year old male came in for retinal evaluation and presented with a melanoma.
|
|

Focal Laser for diabetic macular edema1229 views66 year old female with diabetes for 45 years. VA 20/20 OU. Extrafoveal edema in the left eye treated with light focal laser.
|
|

Uveitis - Iris Nodule - Koeppe Nodule1229 views29-year-old woman has had problems with uveitis in the right eye for about the last two years. Her symptoms are usually floaters. Occasionally the eye gets red, it has not been very uncomfortable, and it has always been in the right eye. Has had Iris Nodule like one in photo in left eye and Right eye. They clear with or without steroids after about a month.
|
|

Multiple - Congenital Hypertrophy of the Pigment Epithelium - CHRPE - Gardner Syndrome1229 views63 Year Old woman with a history of colon cancer at age 32. She has also had thyroid cancer. Two of her 6 siblings died of cancer, one of sarcoma and one of lung cancer. Vision 20/30, 20/25. Fundus shows CHRPE in both eyes.
|
|

Progressive Outer Retinal Necrosis 77 Year Old Woman with CLL (Acute Retinal Necrosis) (PORN - ARN)1228 views77-year-old woman with CLL who had shingles on the left side of her face about 6 weeks ago then she developed a dendrite in the cornea which was treating about four weeks ago. She noticed severe vision loss in the left eye just a few days ago and you saw retinitis and she comes in because of that. Vision OD is 20/25, OS is hand motion
|
|

Hyperpigmentation of the Retinal Pigment Epithelium Right Eye (Treated wet AMD OS)1226 views85-year-old man has wet age-related macular degeneration in the left eye treated for one year most recently one year ago. OD is 20/30, OS is 20/60
|
|

Hypertensive Choroidopathy - Pheochromocytoma - Chronic Very High Blood Pressure 49 YO Male1225 views49-year-old man chronic very high blood pressure sometimes the blood pressure will go as high as 260/160, sometimes it is 200/120 and sometimes it is 160/80. He has a pheochromocytoma on the adrenal gland and he has had vision loss in the right eye starting between three and four years ago.
VISUAL ACUITY: OD 20/60, OS 20/25.
|
|

Retinal Flap Tear - Horseshoe - Cystic Retinal Tuft on Flap1225 views73-year-old woman who noticed two days ago she was bending over and had a sudden “ribbon†in her
vision which looked to her like blood. VISUAL ACUITY: Vision OD is 20/25, OS is 20/20.
|
|
| 17965 files on 180 page(s) |
 |
 |
4 |  |
 |
 |
 |
 |
 |
 |
|